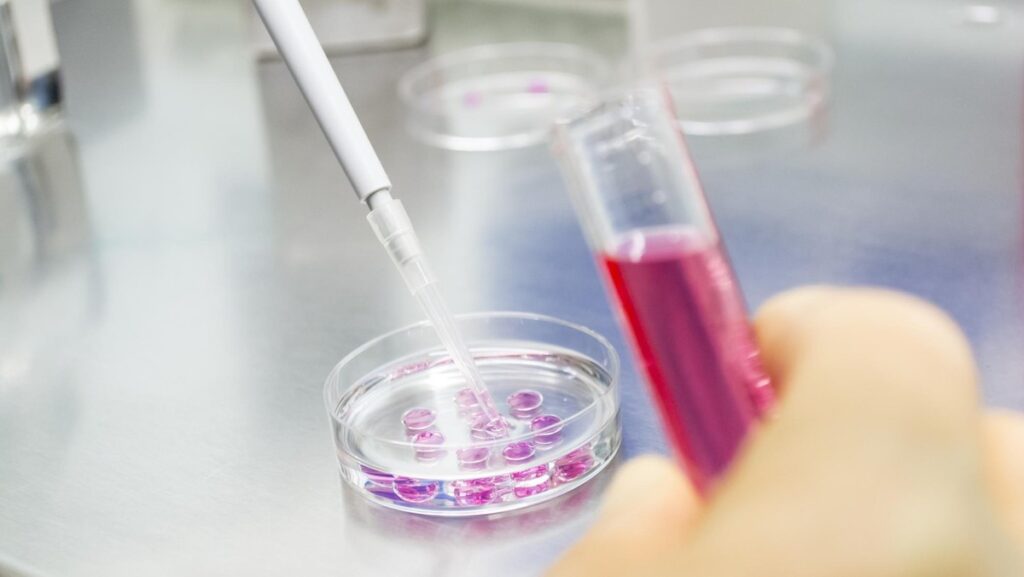
Wow, Ini Dia Kampus Penghasil Penelitian Paling Banyak di Indonesia!

Peneliti Indonesia Berkolaborasi Internasional dengan Pendanaan BRIN
Rifainstitute.com – Badan Riset dan Inovasi Nasional BRIN kembali menunjukkan komitmennya dalam memajukan ilmu pengetahuan. Lembaga ini meluncurkan program pendanaan riset kolaborasi internasional yang menarik. Program tersebut diberi nama BRIN Danapedia Skema Pendanaan Riset dan Inovasi untuk Indonesia Maju RIIM Kolaborasi. Skema pendanaan ini dibuka pada Rabu 11 Februari 2026. Tujuannya adalah mendorong peneliti Indonesia […]
Peneliti Indonesia Berkolaborasi Internasional dengan Pendanaan BRIN Read More »